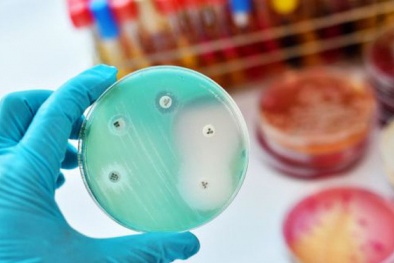
Công nghệ AI: Tìm ra loại kháng sinh mới tiêu diệt vi khuẩn kháng kháng sinh nguy hiểm nhất

Thương hiệu Hội nhập
Công nghệ

Đổi mới sáng tạo – động lực từ toàn dân đến quốc gia
(VietQ.vn) - Đổi mới sáng tạo ở Việt Nam không chỉ là nhiệm vụ của doanh nghiệp hay các nhà khoa học, mà đã trở thành phong trào toàn dân. Khi cả cộng đồng cùng chung tay, đổi mới sáng tạo được lan tỏa thành lối sống, mở ra động lực để đất nước bứt phá.
-

Tin nhắn, hình ảnh, số điện thoại từ WhatsApp dễ dàng bị 'rò rỉ' qua Google Search
Thủ thuật 'biến' điện thoại iPhone thành chiếc cân đồ vật tiện lợi
Cán bộ, người lao động Bộ KH&CN cùng chung tay hiến máu cứu người
Tính năng tìm kiếm tin nhắn hữu ích sắp được nâng cấp của Gmail và cách thức sử dụng
Góc khoa học kỳ lạ: Bào chế thuốc điều trị ung thư từ nọc rắn, nước tiểu bò
Phát hiện loài động vật đặc biệt có thể sống mà 'không thở'
Quy định mới của Châu Âu buộc các nhà sản xuất pin smartphone thay thế loại dễ dùng hơn
-

Đổi mới sáng tạo: Từ 'bài toán khó' của đất nước thành 'cơ hội mới' cho tương lai
-

Nhiều bệnh viện lớn bị tấn công mạng, dữ liệu bệnh nhân bị rao bán trên diễn đàn hacker
Tin mới Công nghệ 24h

Cận cảnh Kawasaki Ninja 650 'cực chất' chuẩn bị về Việt Nam
(VietQ.vn) - Kawasaki Ninja 650 năm 2020 được thiết kế ấn tượng, sắc nét và đầy cá tính, xe có bảng đồng hồ hiển thị mới.

Realme ra mắt điện thoại giá rẻ, được trang bị CPU Helio G70, giá 2,99 triệu đồng
(VietQ.vn) - Realme C3 là chiếc điện thoại giá rẻ với nhiều nâng cấp về thiết kế cấu hình, camera, máy có giá bán 2,99 triệu đồng.

Thủ thuật xóa lịch sử tải xuống trên điện thoại tránh báo đầy dữ liệu
(VietQ.vn) - Thủ thuật xóa lịch sử tải xuống trên điện thoại dùng hệ điều hành Android tưởng chừng đơn giản nhưng nhiều người lại không hề biết.

Những thủ thuật chủ sở hữu Google Home cần biết để tận dụng tối đa loa thông minh
(VietQ.vn) - Nếu bạn sở hữu tiện ích hỗ trợ Google Home hay Google Assistant, những mẹo đơn giản này có thể giúp bạn tận dụng tối đa khả năng công nghệ.

Mỹ bắt đầu thí nghiệm thuốc chống SARS-CoV-2
(VietQ.vn) - Theo Viện Y học Quốc gia, người đầu tiên tham gia thử nghiệm vắc-xin chống SARS-CoV-2 là một công dân Mỹ đã hồi hương sau khi bị cách ly trên con tàu du lịch Diamond Princess.

Sony ra mắt Xperia 1 II cấu hình khủng, giá khoảng 30 triệu đồng
(VietQ.vn) - Sony vừa cho ra mắt chiếc Xperia 1 II (Xperia 1 Mark II), đây là phiên bản kế nhiệm của chiếc Xperia 1 ra mắt vào năm ngoái.

Có gì đặc biệt ở siêu thị tự động không cần thu ngân của Amazon?
(VietQ.vn) - Tập đoàn Amazon vừa khai trương siêu thị tự động không cần thu ngân đầu tiên mang tên Amazon Go. Với siêu thị này, khách hàng sẽ thanh toán trực tiếp bằng cách quét mã QR.

Netflix cho phép người dùng tắt một trong những tính năng gây khó chịu nhất
(VietQ.vn) - Sau tất cả, Netflix đã nới lỏng những quy định và cho phép các tài khoản của mình tắt đi một trong những tính năng gây khó chịu nhất của dịch vụ cung cấp video trực tuyến cực kỳ phổ biến này.

Chế tạo thành công vắcxin ngừa virus corona dạng uống, không gây tác dụng phụ
(VietQ.vn) - Nhóm nghiên cứu của Giáo sư Huang Jinhai ở Đại học Thiên Tân (Trung Quốc) vừa tuyên bố đã phát triển thành công một loại vắcxin ngừa virus corona dạng uống.

Realme X50 Pro 5G trình làng với 6 camera, giá khoảng 15 triệu đồng
(VietQ.vn) - Realme X50 Pro 5G vừa ra mắt được trang bị chip Snapdragon 865, thiết lập bốn camera sau và hỗ trợ công nghệ sạc nhanh 65 W.

'Cuộc đua' chế tạo bộ kit test nhanh virus corona: Quốc gia nào đang nắm lợi thế?
(VietQ.vn) - Nhiều nhóm khoa học thuộc nhiều quốc gia trên khắp thế giới đang làm việc gấp rút để phát triển các bộ kit test nhanh virus corona với mục tiêu rút ngắn tối đa thời gian cho kết quả sau chẩn đoán.

Tuyển chọn thực hiện 3 đề tài khoa học và công nghệ độc lập cấp quốc gia
(VietQ.vn) - Bộ Khoa học và Công nghệ đã phê duyệt danh mục 03 đề tài khoa học và công nghệ độc lập cấp quốc gia để đưa ra tuyển chọn bắt đầu thực hiện từ năm 2020.

An ninh mạng Viettel xây dựng hệ sinh thái giải pháp an toàn thông tin
(VietQ.vn) - Công ty An ninh mạng Viettel (Viettel Cyber Security- VCS) là công ty an toàn thông tin đầu tiên của Việt Nam xây dựng được một hệ sinh thái giải pháp do chính các chuyên gia trong nước nghiên cứu và phát triển.

MobiFone: Gói cước C120 gọi điện thỏa thích, "lướt" net thả ga
(VietQ.vn) - Khi xu hướng "cá nhân hóa" ngày càng được chú ý thì những gói cước data của MobiFone càng đa dạng để có thể đáp ứng theo tiêu chí của từng nhóm đối tượng khách hàng với chi phí rẻ mà tốc độ tốt nhất. Khách sẽ dựa theo tiêu chí của từng gói data để lựa chọn, đảm bảo tốc độ ổn định, nhanh và đúng nhu cầu thực tế. Đặc biệt là gói cước C120 sẽ mang đến cho khách hàng những ưu đãi khủng về data và số phút thoại.

Covid-19 có thể ảnh hưởng điện thoại Galaxy S20, Z Flip
(VietQ.vn) - Samsung cho biết tạm đóng cửa nhà máy sản xuất điện thoại cao cấp tại Gumi (Hàn Quốc) vào cuối tuần qua do có công nhân nhiễm Covid-19

Thiết bị thông minh giúp robot có suy nghĩ giống với con người
(VietQ.vn) - Các nhà khoa học Mỹ vừa phát triển thành công một thiết bị thông minh mô phỏng đường dẫn thần kinh của những tế bào não, trong hệ thống thị giác của con người.

Đến năm 2025, khoa học và công nghệ sẽ đóng góp 40% vào tăng trưởng kinh tế
(VietQ.vn) - Việt Nam đặt mục tiêu vào năm 2025, thông qua yếu tố năng suất các nhân tố tổng hợp (TFP), hoạt động khoa học và công nghệ sẽ đóng góp khoảng 40% vào tăng trưởng kinh tế.
Công nghệ AI: Tìm ra loại kháng sinh mới tiêu diệt vi khuẩn kháng kháng sinh nguy hiểm nhất
(VietQ.vn) - Công nghệ AI đã giúp các nhà khoa học thực hiện những điều không tưởng trong nghiên cứu khoa học

Thủ thuật kiểm tra điện thoại iPhone ‘tân trang’ tránh mất tiền oan
(VietQ.vn) - Mua điện thoại iPhone ‘tân trang’ dù có giá rẻ nhưng thực tế khi sử dụng loại điện thoại này sẽ gặp không ít rủi ro.

Dùng thuốc chữa HIV để điều trị virus corona: Bao giờ công bố kết quả?
(VietQ.vn) - Theo Tổ chức Y tế Thế giới (WHO), kết quả sử dụng thuốc chữa HIV để điều trị bệnh do virus corona sẽ có vào tháng 3 tới.





